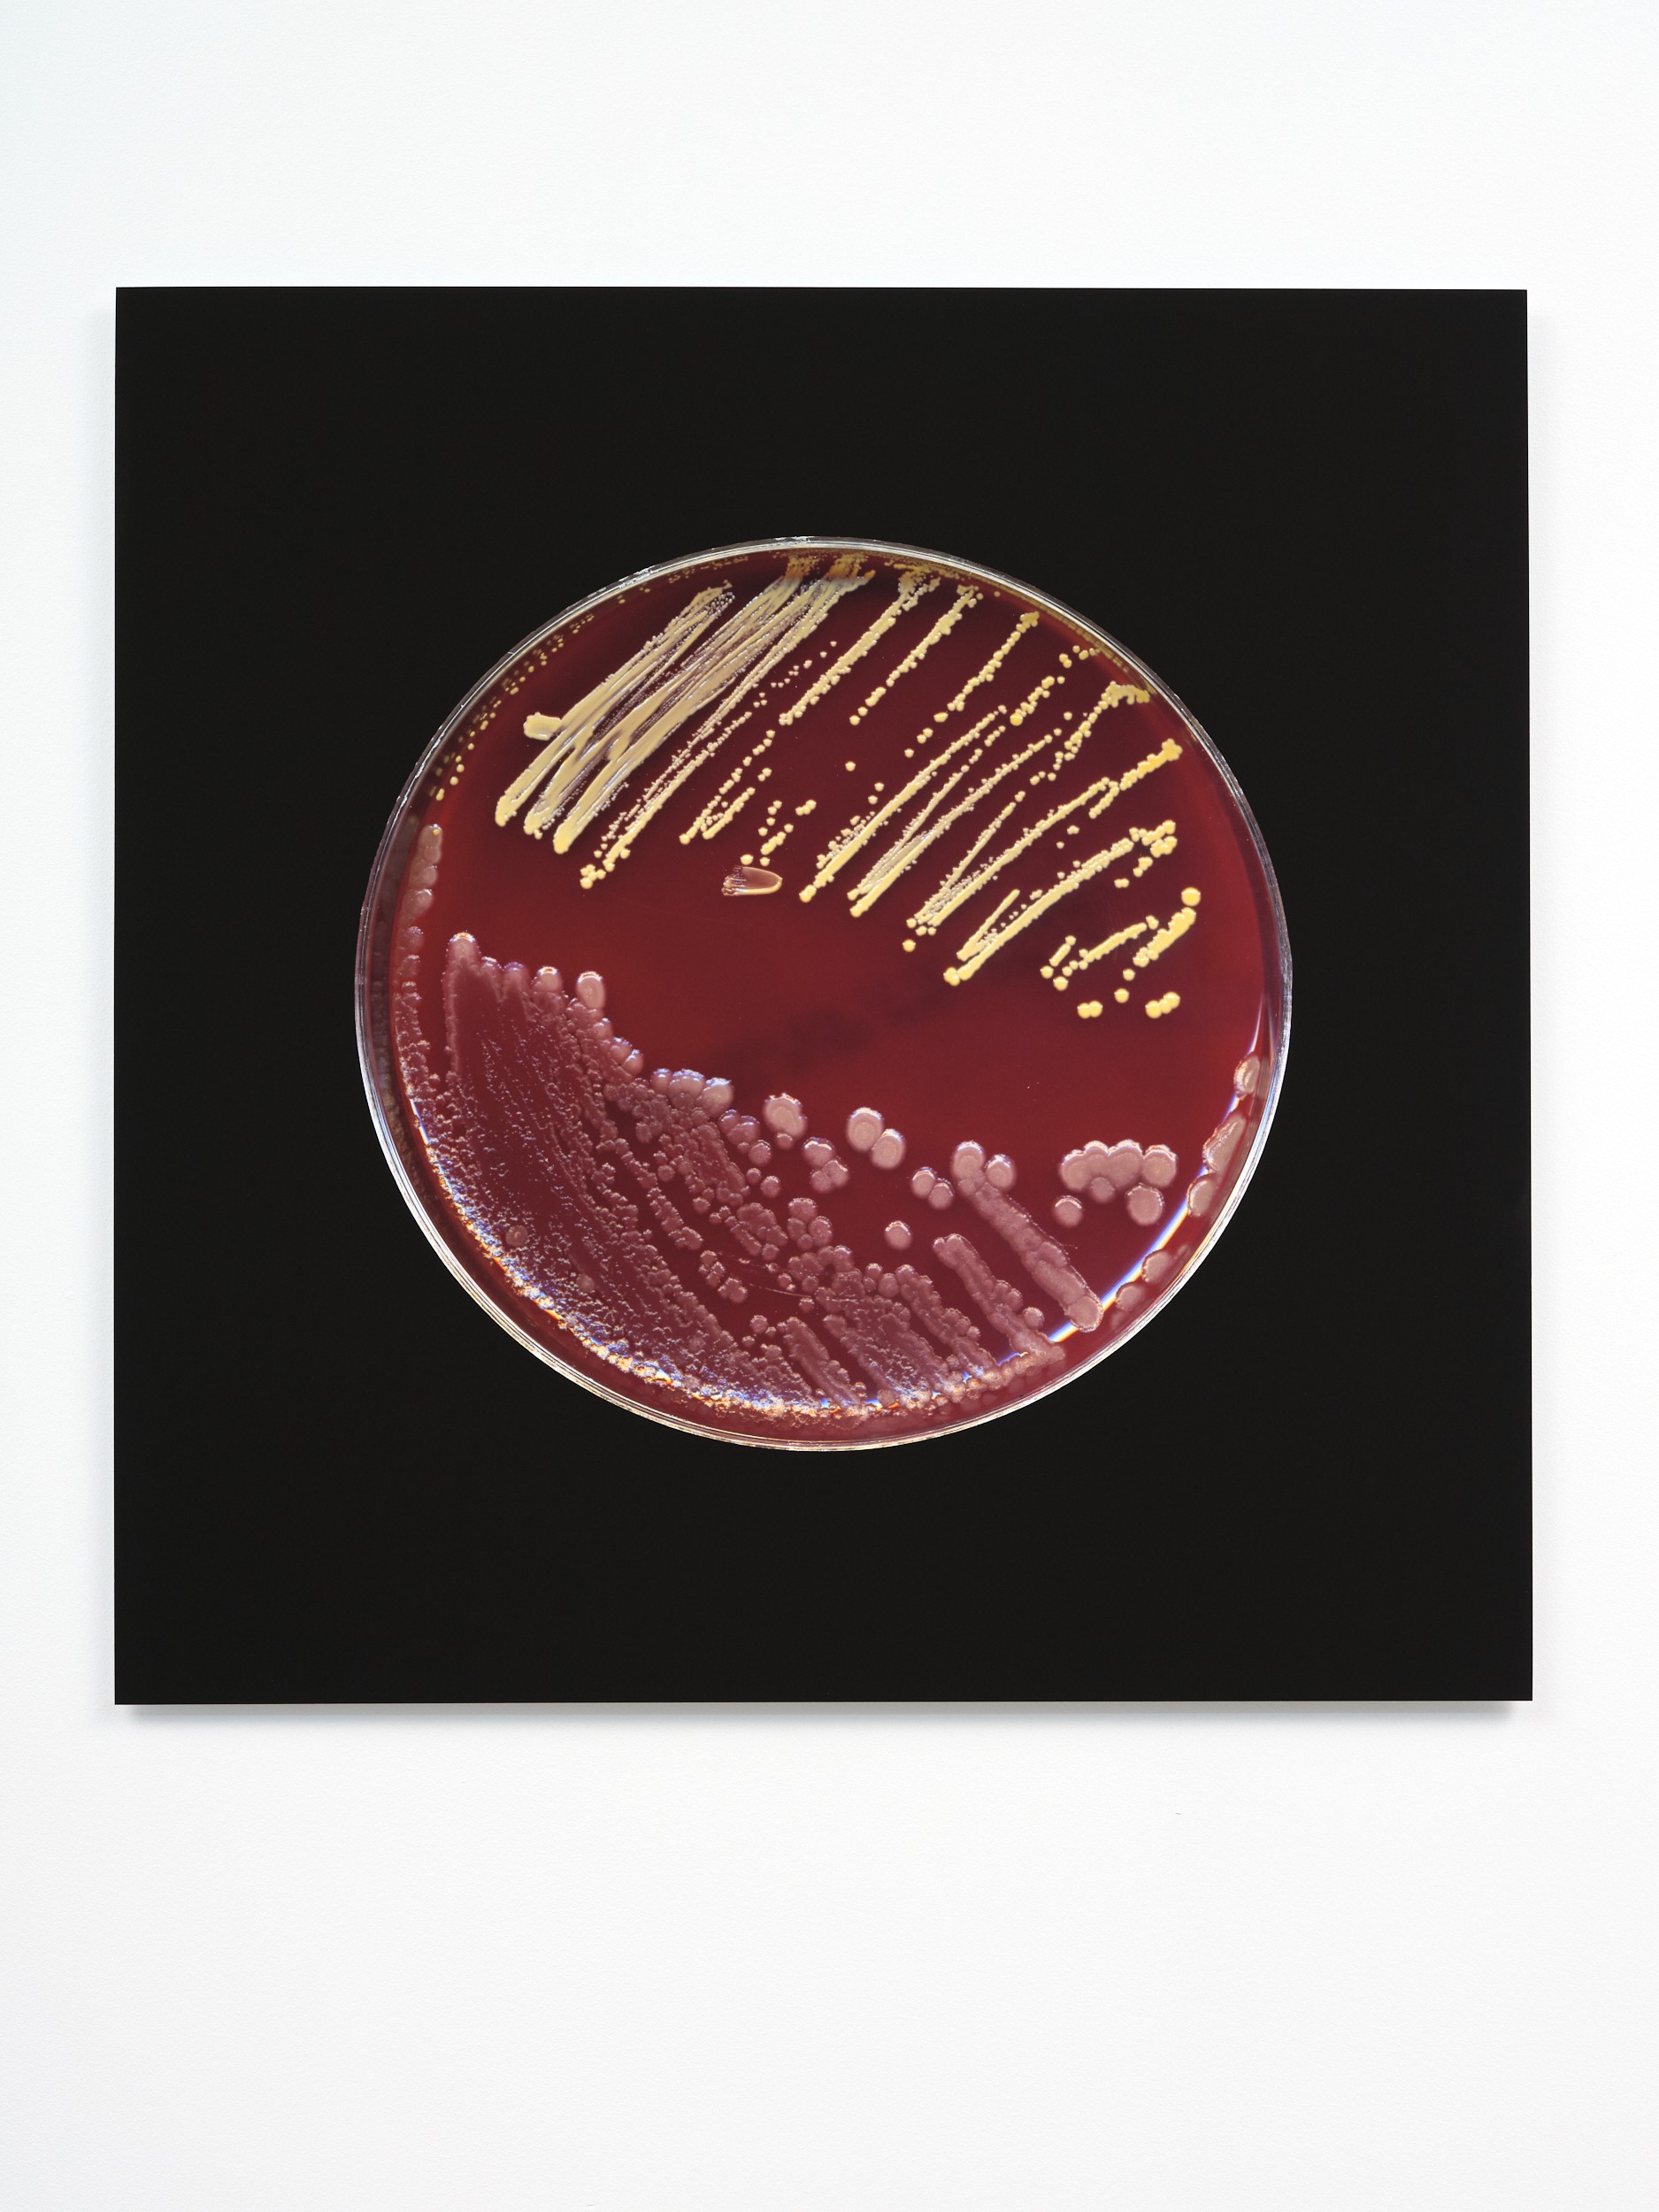

Dane Mitchell
From the Dust Archive (Museum of Modern Art)
2003/2021(printed)
800 x 800 mm
archival inkjet print on dibond (matte enhanced paper)
Edition 2 of 3
Estimate: NZD 8,000 — 12,000
Bidding has closed - thank you!
Working somewhat as a conceptual centrepiece for When The Dust Settles, Dust Archive by Dane Mitchell is an ongoing work that started in 2003 in which the artist collects pieces of dust from various global contemporary art institutions.
Highly political in nature, the archive maps, activates on the one hand a notion of collecting institutes and museums as ‘dusty’ places that contain both cultural and biological residue, and on the other hand confirms the way that our bodies entering these spaces leave inevitable traces within these institutions.
We also know of the information dust and particles give us, long after it has been created. This is apparent in the continuous analysis of particles of the 2001 collapse of the Twin Towers in New York in which today we can read micro-stories through organic and non-organic material, long after the event. In Mitchell’s case, Dust Archive is part of an equally meticulous and precise artistic practice that redefines what we can read and analyse from the dust itself, beyond what lies on the surface.
Dust, and the archiving of it, embody Mitchell’s long-term research approach in which an evolving interpretation of information, as well as the change in the materials themselves, are brought to the forefront. The choice here of collecting dust from hundreds of international art institutions signals the changing hierarchies of these entities and suggests that ‘when the dust settles’, everything will return to dust.
Artist Biography & History
with Artspace Aotearoa:
Exhibited
Radiant Matter III (solo), 05 July — 20 August 2011
Local Transit (group), 20 May — 1 July 2006, curated by Christian Rattemeyer and Brian Butler. Mitchell’s work was exhibited at Artists Space, New York, as part of this two-part exhibition exchange between Artists Space and Artspace, Tāmaki Makaurau Auckland.
Free New Zealand Art (group), 16 March — 16 April 2005
Money For Nothing (group), 10 May — 29 June 2003
Only The Lonely: New Artists Show 1999 (group), 9 June — 2 July 1999
Published
Dane Mitchell’s work was nominated by Natasha Conland to be included in Speculation, a publication produced in 2007 as New Zealand’s contribution towards the 52nd Venice Biennale at a time when Government funding for New Zealand at Venice was under review. Speculation was edited by Brian Butler, then director of Artspace.
Dane Mitchell
Dane Mitchell’s practice is concerned with the physical properties of the intangible and visible manifestations of other dimensions. His practice speculates on what is material and explores systems of knowledge or belief and relational aspects or experiences of these. Often dealing with the way things transform or transmit and the presence of material forces and the unseen, in his work invisible phenomena are transmuted into tangible forms as sculptural objects, images and sound, connecting the sensual and the cognisant, and teasing out the potential for objects and ideas to appear and disappear.
Dane Mitchell represented Aotearoa New Zealand at the 58th Venice Biennale. Mitchell’s work has been included in major exhibitions including, Venice Biennale (2019); Bangkok Biennale (2020); Biennale of Sydney (2016); Liverpool Biennial (2012); Gwangju Biennale (2012); Singapore Biennial (2011); Thailand Biennale (2018); Busan Biennale (2010) and 29th Graphic Arts Biennial Ljubljana (2011). In the recent past he has had solo exhibitions at public institutions including Mori Art Museum, Tokyo; Auckland Art Gallery Toi o Tāmaki, Tāmaki Makaurau Auckland; Christchurch Art Gallery Te Puna o Waiwhetū, Ōtautahi Christchurch; Institut D’Art Contemporain, Villeurbanne, amongst many others.

Installation view: When, the first instalment of When The Dust Settles at Artspace Aotearoa, August 2021

Installation view: When, the first instalment of When The Dust Settles at Artspace Aotearoa, August 2021

Installation view: When The Dust Settles at Artspace Aotearoa, October 2021

Photograph documenting the theft and travels of Artspace’s sandwich board in 1998, courtesy of Dane Mitchell

Photograph documenting the theft and travels of Artspace’s sandwich board in 1998, courtesy of Dane Mitchell

Photograph documenting the theft and travels of Artspace’s sandwich board in 1998, courtesy of Dane Mitchell

Photograph documenting the theft and travels of Artspace’s sandwich board in 1998, courtesy of Dane Mitchell

Photograph documenting the theft and travels of Artspace’s sandwich board in 1998, courtesy of Dane Mitchell

Installation view: Radiant Matter III (solo), 05 July — 20 August 2011
Dust Archive by Christian Rattemeyer
Originally published in North Drive Press no.4 (2007), New York.
Dust is a marker of activity and inactivity alike. It occurs as a byproduct of all activity, and yet most commonly marks and attacks those zones and objects that appear inactive, defunct, resting. Dust is a great indicator of time passed. As such, it is not without merit: While it commonly might be considered harmful or a sign of neglect, it also bestows historicity upon its bearers, marking the rank, random object as old, antique, even rare on occasion. Thus, dust is a great paradox in the world of institutionalized history, the museum. Often a prerequisite for its objects of care, it is to be avoided once these enter the sphere of museological influence. Dust is allowed on a thing; never in a building.
Marcel Duchamp, of course, was the first great modern philosopher of dust: his Large Glass languished in his studio for years, collecting dust, where Man Ray photographed the surface in 1920 for the famous image Dust Breeding. During these years, Duchamp would sometimes refer to his professional activity as dust breeding, and the outcome is spectacular as ever. Lunar and evocative, the dust turns the underlying patterns into ridges and pathways, craters and valleys and geometric forms only equaled by the monumental efforts of Land Art. Dust here is a creative force, a contrasting agent revealing in a new light that which without it would appear idle and unfinished.
But dust is also a truly democratic force, able to contain all and everything, and settle almost everywhere; a resident of every crevice and country, and a representative of all things, organic and inorganic. As Dane Mitchell writes, "the particles that lurk in corners and recesses contain everything from space stones to Saharan dust, from fungi to the bones of animals, bits of modern tire rubber, poisonous lead, long banned pesticides, dangerous molds and bacteria and countless micrograms of human skin. Such clusters are riddled with allergy-inducing dust-mite parts, with the mites themselves, and with the pseudo-scorpions that stalk and kill them."
Mitchell's Dust Archive (begun in 2003) might be seen as an investigation into the politics of dust, or maybe represents a scientific analysis; possibly, it is a philosophical tract about the ubiquity and unavoidability of its subject, a study in the failure of a Sisyphean labor to repel dust. The project involves the ongoing collecting and building of an archive of dust from museums and galleries around the world (predominantly those with collections - this is true but for a couple of exceptions) - so far the archive contains samples from 160 institutions. It displays all the hallmarks of conceptual practice: the studious longevity of its research-based accumulation, the neutral, quasi-scientific display paradigms, the benign critique launched at the institutions of art, and the administrative language of non-art. But it fails to deliver the ideological punch that practices of institutional critique meant to deliver: is there a form of unalienated dust, or a difference between its socialist and capitalist varieties? Are there forms of dust occurrence that are truer to the artworks' intentions in the institution's care, or less discriminatory in effect?
In the end, Mitchell's Dust Archive comes closest to a study of the environments of all art: more accurate than the most ambitious sociological study, more historical in time than the most far-reaching research papers, more diverse than the broadest sample group. It is a record of all that comes to visit art in its different and multifarious homes, and thus represents the potential, eternal audience: for we all come from dust, and to dust we shall return.
Bidding has closed - thank you!
Back to all artworks